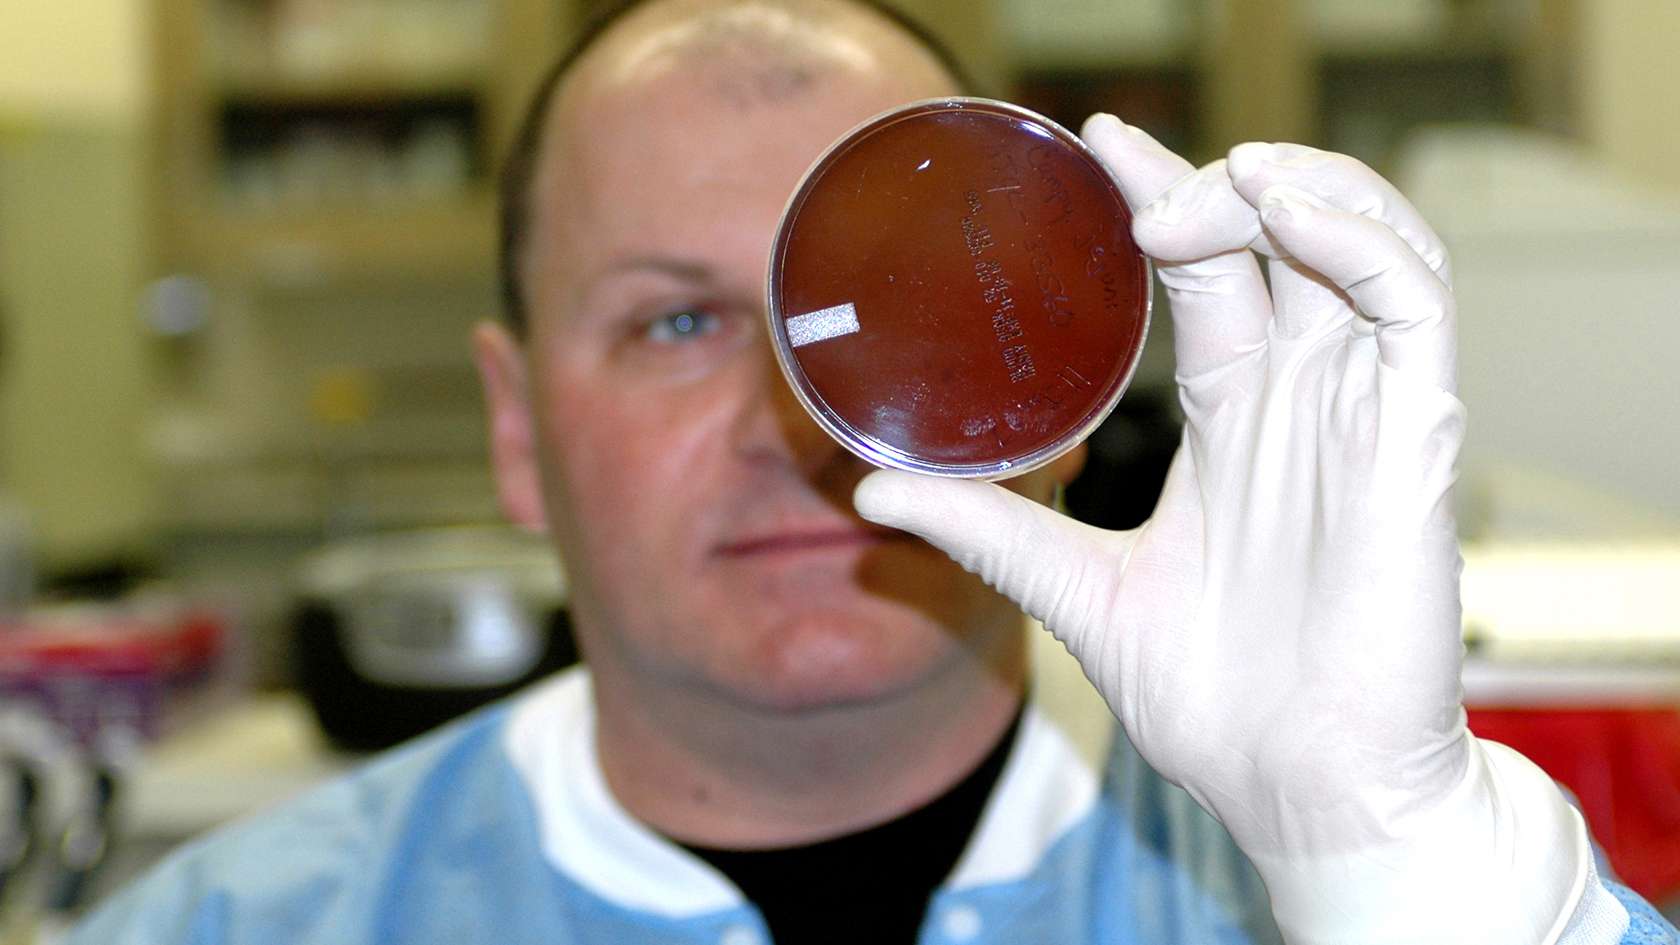
Air Force Histopathologist looking at petri dish

Enlisted HISTOPATHOLOGY
What you’ll do
- Receive and prepare surgical specimens for tissue diagnosis
- Maintain records of all surgical, cytological and autopsy specimens
- Serve as a technical assistant during autopsies
- Evaluate current and new procedures for implementation and effectiveness
- Assist in maintaining accreditation standards

TRAINING & EDUCATION
How do we transform you from a raw recruit to an expert Airman in this field? From hands-on experience to college credit toward a degree, the path begins here.
-
Basic Military Training
7.5 weeks
-
TECHNICAL TRAINING
180 days
-
TECH SCHOOL LOCATION
Ft. Sam Houston, TX
-
STATUS UPON COMPLETION
Enlisted Airman with credits earned towards Histologic Technology
-
You must be 17–42 years of age, a U.S. citizen and obtain a qualifying ASVAB score.
*High School Students may start their application as early as the end of their junior year.
-
44 General (G)
-
- Normal color vision
- Completion of 7.5 weeks of Basic Military Training
- Must be at least 17, but has not reached age 42 on the date of enlistment





